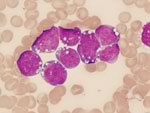

заболевание лимфома
Вопросы и ответы по: заболевание лимфома
Мне 26 лет. Шесть лет назад увеличились 2 лимфоузла - один на шее, другой около позвоночника. Когда-то в детстве болел туберкулезным бронхоаденитом, поэтому врачи поставили схожий диагноз. Лимфоузлы большие, но безболезненные. Поначалу была небольшая температура и кишечные расстройства, но через 3 года всё прекратилось, остались только увеличенные лимфоузлы. И вот, спустя ещё 3 года, появились неприятные ощущения в спинном лимфоузле, в мышцах спины, а также небольшая слабость организма. В любом случае, пойду на диагностику, но, начитавшись разнообразных статей, боюсь это делать.
Правильно ли я понимаю, если бы это было онкологическое заболевание (лимфома, например), то за 6 лет с момента заболевания оно проявилось бы с совсем другой силой? Насколько вероятен вариант с вирусным поражением лифмоузлов? Подскажите, пожалуйста.
Заранее спасибо за ответ!
Проводились такие химиотерапии(это последние химиотерапии до этого были такие же с меньшей дозой):
Эндоксан 1200мг №2
Этопозид 190мг №3
Прокарбазин 1000мг
Медрол 80мг
Еще один курс химиотерапии:
Эндоксан 2400мг
Этопозид 570 мг
Прокарбазин 1000мг
Медрол 800мг
Сейчас назначено таблетированая терапия:
Эндоксан 50 мг сут.
Прокарбазин 50 мг сут.
Ластет 50мгсут.
Медрол 32мг сут.
И наблюдение местного онколога.По заключению узи органы печень,селезенка,желчный пузырь,почки не увеличены.Признак обьемного образования мягких тканей передней грудной клетки слева ,вероятнее имеет место заболевание,признаки левостороннего гидроторокса вторичного поражения забрюшинных лимфоузлов.
Помогите пожалуйста советом.
В ноябре 2013 года у меня был тромбоз сурральных вен правой конечности, пролечили. На фоне варфарина в декабре был повторный тромбоз сурральных вен правой конечности, добавился тромбоз поверхностных. В конце декабря 2013 года на УЗИ выявили увеличенные лимфатические узлы под правой коленкой. После лечения тромбоза сохраняется скованность в коленном суставе. Остальные лимфатические узлы при осмотре не пальпируются, самочувствие и анализы крови хорошие.
По мрт в подколенной ямке визуaлизируются четыре округлrых образования мягкотканой плотности
рзмерами 3,5х2,85х2,86см, 2,74х1,76х1,9Зсм, 1,4х1,3х1,0см, 2,8х2,57хЗ,3см. структура
образований однородная, стенки достаточно четкие, небольшой отек тканей вокруг образований.
Сосудистый пучек в подколенной ямке несколько оттеснен.
Сейчас врачи настаивают на выполнение биопсии подколенного лимфатического узла, гистологии и ИГХ для определения дальнейшей тактики лечения.
Меня беспокоит расположение, опасаюсь лимфостаза или других последствий биопсии. Насколько велика возможность осложнений после биопсии подколенного узла? За 3 недели динамики в состоянии нет. Гематологи говорят, что очень странная локализация, очень нетипичная, не похожа на лимфому. Принимаю ксаредто по 1 таб. сохраняется скованность в коленном суставе и небольшая отечность коленки. Может ли тромбоз привести к росту лимфатических узлов или наоборот тромбоз следствие лимфомы? Могут ли быть другие объяснения увеличенных лимфатических узлов и тромбозов, кроме моего основного заболевания?
лейкоциты -3.42(4.50-11.00);
нейтрофилы сегментояд. - 42(47-72);
нейтрофилы (общ.число)- 45 (48.0-78.0);
лимфоциты - 44 (19.0-37.0).
Остальные показатели в пределах нормы.
Спасибо!
Список ранее существовавших болезней, которые по версии ВОЗ теперь называются СПИДом
(в скобках указаны уже известные возбудители соответствующих заболеваний):
Кандидоз трахеи (вызывается дрожжеподобными грибками типа Candida).
Кандидоз бронхов (вызывается дрожжеподобными грибками типа Candida).
Кандидоз легких (вызывается дрожжеподобными грибками типа Candida).
Кандидоз пищевода (вызывается дрожжеподобными грибками типа Candida).
Кокцидиомикоз - хронический глубокий микоз, поражающий кожу, легкие, пищеварительный тракт (вызывается паразитическим грибком Coccidioides immitis).
Криптококкоз внелегочный (вызывается паразитическим дрожжеподобным несовершенным грибком Cryptococcus).
Криптоспородиоз кишечника - протозойная инфекция, вызываемая Cryptosporidium muris и parvum.
Гистоплазмоз диссеминированный или внелегочный (вызывается грибком Hystoplasma).
Изоспороз кишечника (вызывается споровиками Isospora).
Сальмонеллезные септицемии (возбудители сальмонеллы).
Туберкулез легких (возбудитель микобактерия туберкулеза).
Туберкулез внелегочный (возбудитель микобактерия туберкулеза).
Другие микобактериозы.
Пневмоцистная пневмония (возбудитель Pneumocystis carini).
Пневмонии возвратные - 2 раза и более в течение года.
Простой герпес (вызывается вирусом Herpes simplex).
Цитомегаловирусная инфекция с поражением других органов, кроме печени, селезенки, лимфатических узлов (вызывается цитомегаловирусом).
Цитомегаловирусный ретинит (вызывается цитомегаловирусом).
Саркома Капоши - преимущественное поражение кожи с генерализованным новообразованием кровеносных сосудов и расширением капилляров с образованием многочисленных полостей, выстланных набухшим эндотелием.
Лимфома Беркитта - злокачественная лимфома вне лимфатических узлов.
Иммунобластическая саркома.
Лимфома мозга первичная.
Рак шейки матки (инвазивный).
Прогрессирующая многоочаговая лейкоэнцефалопатия.
Токсоплазмоз мозга (вызывается внутриклеточным паразитом Toxoplasma gondii).
Синдром истощения
Популярные статьи на тему: заболевание лимфома

Неходжкинские лимфомы остаются одной из наиболее сложных проблем современной онкологии. Ежегодно уровень заболеваемости повышается на 2-3% и за последние 20 лет увеличился практически вдвое.

В статье отражены современные представления о методах первичного выявления Helicobacter pylori и контроля ее эрадикации у пациентов с H.pylori-ассоциированными заболеваниями гастродуоденального сегмента.

Функциональная диспепсия – симптомокомплекс функциональных нарушений, включающий в себя боли или ощущение дискомфорта в эпигастральной области.

Историческая справка Вопросы диагностики и лечения лейкозов и других опухолевых заболеваний кроветворных и лимфоидных органов всегда были в центре внимания отечественных ученых — клиницистов-гематологов и гематопатологов. Родоначальником...

Открытие Helicobacter pylori (НР) как одного из ведущих этиологических факторов в возникновении деструктивной гастродуоденальной патологии изменило наше представление о патогенезе этих заболеваний и радикально повлияло на стратегию и тактику лечения.

Лимфома крови – это не одна самостоятельная болезнь, а целая группа заболеваний, которые отличаются между собой в некоторых особенностях протекания и вместе с тем объединены одним общим признаком.

Лимфома Ходжкина – злокачественная опухоль из атипичных лимфатических клеток, названная в честь первооткрывателя Томаса Ходжкина. Является одним из клеточных вариантов лимфогранулематоза. Остальные виды лимфогранулематоза называют неходжинскими лимфомами.

Крапивница представляет собой одно из наиболее распространенных аллергических заболеваний, которому подвержены люди любого возраста.

Заболевания, ассоциированные с Helicobacter pylori, являются актуальной проблемой современной гастроэнтерологии. Вопросам диагностики и лечения хеликобактерной инфекции уделяют особое внимание на медицинских конференциях.
Новости на тему: заболевание лимфома

Пациенты, которые перенесли заболевание лимфогранулематоз или лимфома Ходжкина в детском или подростковом возрасте, более склонны к развитию определенных видов онкологических заболеваний по сравнению с другими людьми
Датские ученые предоставили данные о том, что ими был найден эффективный метод терапии редкой формы лимфомы - онкологического заболевания, которое до сегодняшнего дня считалось неизлечимым

Одним из внепеченочных проявлений вирусного гепатита С может быть синдром Шегрена, заболевание аутоиммунного происхождения, которое в свою очередь повышает риск развития опухолей лимфатической системы и онкологических заболеваний крови.

Появление в арсенале онкологов препарата ритуксимаб позволило им добиться прогресса в лечении неходжкинской лимфомы. Инструкции требуют медленного внутривенного введения препарата, а британские ученые предлагают вводить его подкожно всего за 5 минут.

В последние год-два на высших руководителей стран Латинской Америки словно обрушилась эпидемия онкологических заболеваний: в ближайшие дни лечение по поводу рака начнет уже пятый президент государства из этого региона.

В последние годы ученые разных стран получили убедительные доказательства связи диабета с такими онкологическими заболеваниями как рак печени и поджелудочной железы. А исследователи из США обнаружили, что диабет повышает и риск развития лейкозов.

Минувшее десятилетие ознаменовалось настоящим бумом пластических операций по улучшению внешности, среди которых абсолютным лидером являются операции по увеличению груди с помощью силиконовых имплантантов. Считается, что подобные операции при соблюдении всех правил являются совершенно безопасными для здоровья женщин, однако последние сообщения американских исследователей не могут не вызвать тревогу: обнаружена связь между наличием в организме имплантантов и повышением риска развития редкой, но очень опасной формы рака – анапластической крупноклеточной лимфомы; эта опухоль появлялась в тех крохотных и практически незаметных шрамах, которые оставались после операции.

Хорошо известные и более 20 лет применяемые для лечения депрессий препараты Прозак и Анафранил, как выяснили британские медики, обладают и выраженной противоопухолевой активностью. Высокую активность оба антидепрессанта проявили против таких заболеваний как лейкемия и лимфома. Кроме того, применение препаратов-антидепрессантов усиливает действие специальных лекарств, предназначенных для борьбы со злокачественными опухолями.

Лечение рака «радиоактивными пулями» даёт новую надежду неизлечимым больным лимфомой Ходжкина. Две трети больных после эксперимента положительно отреагировали на лечение с помощью этого метода. Новая терапия называется CHT25 и использует радиоактивные изотопы, которые вводятся в поражённое место и выборочно борются с клетками лимфомы.








